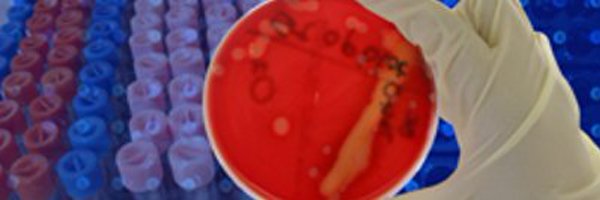
capath Profile Banner

Ca Pathologists
@capath
Followers
1K
Following
179
Media
935
Statuses
2K
The premier state organization of pathologists for pathologists. Providing education, advocacy, government relations and practice management.
Sacramento, CA
Joined February 2009
⏰ Last call: Pre-register by Nov 21 for CSP 2025 in Long Beach! Register: https://t.co/C5Wkt8P3tV
#CSP2025 #Pathology
0
1
0
📅 CSP 2025 Annual Meeting 🗓️ Pre-Register by Nov 21! 🔬 Gyn + Breast Pathology 🧫 Interactive Microscopy 🎓 20 AMA PRA Credits™ 🤝 Network | 🌊 Long Beach 👉 https://t.co/lKQ8jDN61J
#Pathology #CSP2025 #GynPath #BreastPath #MedTwitter
0
1
1
🌴 Earn up to AMA PRA Category 1 Credits™ at CSP 2025 in Long Beach, Dec 4-6! Register: https://t.co/C5Wkt8P3tV
#CSP2025 #Pathology
1
3
6
James Kim is a first year medical student at Drexel University College of Medicine. Watch James play Chopin's Ballade No. 4 in F minor for CSP! Thank you! https://t.co/rDAIbMK0rX
#cspath #cspathol #pathologymusic #pathologypiano
0
0
1
Connect at CSP 2025 in Long Beach, Dec 4-6! 🌴 Network at receptions & hear Dr. Ritu Nayar on cervical cancer screening. Register: https://t.co/2AeR1MnPYF
#CSP2025 #Pathology
0
0
0
📣 Final call! Abstract deadline for CSP 2025 Annual Meeting (Dec 4-6, Long Beach, CA) is tomorrow, Sept 30, 2025! Trainees, submit your pathology research/case reports for a chance to present & win awards! https://t.co/C5Wkt8P3tV
#Pathology #MedEd #CSP2025
0
0
0
⏰ 5 days left of CSP 2025 Early Bird Pricing! Join us in Long Beach, Dec 4-6. Register: https://t.co/C5Wkt8P3tV
#CSP2025 #Pathology
0
0
0
🌴 CSP 2025 in Long Beach! Dec 4-6. Earn up to 20 AMA PRA Category 1 Credit(s)™. Register by Sept 30: https://t.co/C5Wkt8P3tV
#CSP2025 #Pathology
0
3
5
📣 Abstract deadline extended to Sept 30, 2025 for the CSP 2025 Annual Meeting (Dec 4-6, Long Beach, CA)! Trainees, submit your research/case reports in pathology. Top posters win awards! Details: https://t.co/C5Wkt8P3tV
#Pathology #MedEd #CSP2025
0
0
0
📝 Last call: CSP 2025 posters due Sept 8! Long Beach, Dec 4-6. Register: https://t.co/C5Wkt8P3tV Top posters win awards!🏆 #CSP2025 #Pathology
0
0
0
CSP 2025 in Long Beach Dec 4-6 at the Westin. Register: https://t.co/C5Wkt8P3tV Submit posters by Sept 8! #CSP2025 #Pathology
0
0
0
FSP offers 6 free CMEs via online learning on molecular pathology, biomarker testing, digital pathology and AI, accessible from anywhere, including the comfort of their homes. #CSPath #FSP #CME #Pathology
0
0
1
🌴 Busting CSP Myths! Myth: “CSP = San Francisco.” ❌ Wrong! CSP is for ALL California pathologists. Join us in Long Beach, Dec 4-6, 2025, for connection & learning. Register now: https://t.co/C5Wkt8P3tV
#CSP2025 #Pathology
0
0
0
🌴 2025 CSP Annual Meeting in Long Beach, CA! 📅 Dec 4-6 Join us for pathology sessions & SoCal vibes! 🐋🍹 Explore the Aquarium of the Pacific, Queen Mary, whale watching & more! 🌅 Details: https://t.co/lKQ8jDN61J
#CSP2025 #Pathology #LongBeach
0
0
0
🚨 Registration is OPEN for the CSP 2025 Annual Meeting! 📅 Dec 4-6, Long Beach, CA. Join pathologists for top CME, networking, and cutting-edge research. Secure your spot: https://t.co/lKQ8jDN61J
#CSP2025 #Pathology
0
0
0
🌟 Sponsor with CSP and Reach California's Pathology Community! 🌟 📩 Reserve your spot today and put your brand front and center with California’s pathology leaders! 👉 For more info or to sponsor, visit our website: https://t.co/xRQBXnYXup
#Pathology #MedicalEducation #CSP2025
0
0
0
🚨 Sponsor the 78th CSP Annual Meeting – Limited Spots! 📅 Dec 4–6, 2025 | 📍 Long Beach, CA Showcase your brand to 200+ board-certified pathologists! 🔹 Sponsor levels from $3K 🔹 Year-round visibility via ads & webinars 🔗 https://t.co/MoAcD7P0Pq
#CSP2025
0
0
0
🏨 Exhibitors — Book Your Stay! Stay steps away from the action at The Westin Long Beach 📍 333 E. Ocean Blvd, Long Beach, CA 💲 Room Rate: $264 (single/double) 🛑 Cut-off: Nov 10, 2025 or until sold out! https://t.co/oBycSyZ92f
#PathologyEvent #MedicalExhibitor #BookNow
0
0
0